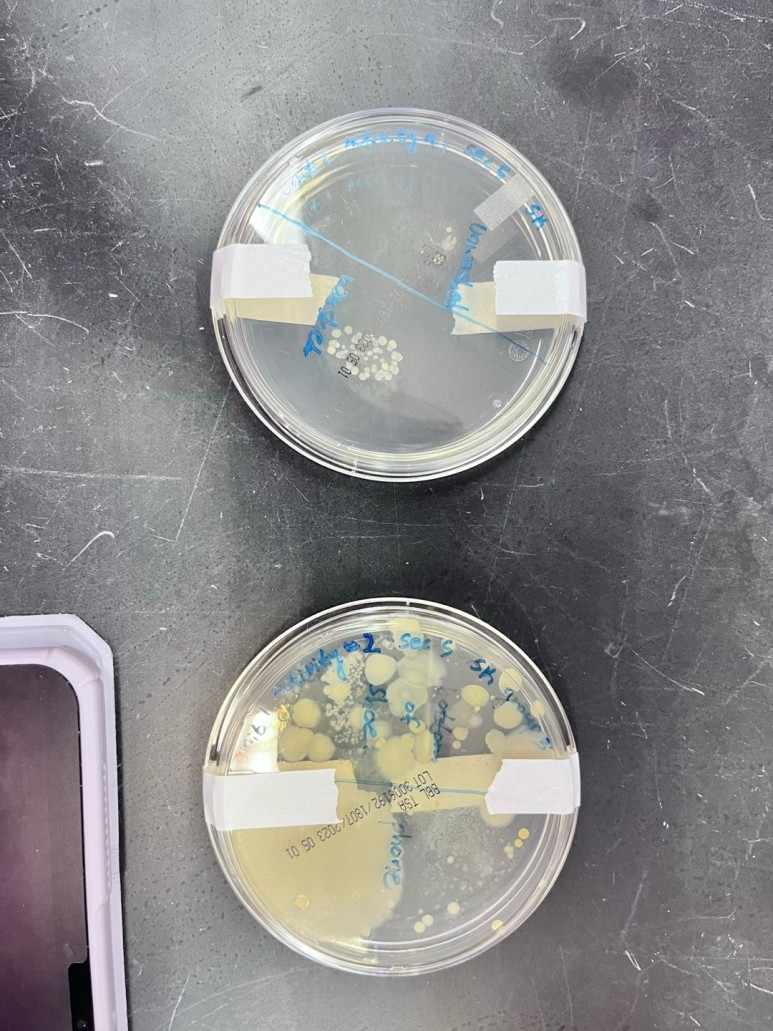

안녕하세요! 케네쏘 주립대 2학년 1학기를 끝낸 김*영이라고 합니다.
이번 학기에 간호대 입학 시험 TEAS를 끝냈고 간호대 application을 넣어서 결과를 기다리고 있는 상태입니다.
TEAS는 87%를 받았고, 권장 점수인 79% 이상인 점수여서 이 시험 점수로 application을 넣었습니다. 이번 학기는 지금까지 보냈던 학기들보다 제일 바쁘고 어려웠던 학기였던 것 같습니다.
1. Anatomy&Physiology II/Lab (BIOL 2222/L)
이 수업은 인체의 11 system들을 배우는 수업이여서 저번 학기에 들은 anatomy&physiology I을 이어서 심장, 피부, 뼈 등등을 배우는 과정이였습니다. 이 수업이 간호대 입학 전에 들어야 하는 수업 중에서 제일 어렵다고 하는 수업입니다. 그런만큼 지금까지 들었던 수업들 중에서 제일 어려웠고 그런만큼 과제가 많아서 힘들었던 수업이였습니다. Lab도 재미있었지만 그만큼 외울게 많았습니다. 매주 해야하는 숙제, 퀴즈, 시험, 리딩이 많기 때문에 시간도 많이 잡아먹었던 수업이였습니다.

1. Foundations of microbiology/lab (BIOL2260/L)
미생물학을 배우는 수업으로 간호대 pre requisite (간호대 입학 전에 들어야 하는) 수업이였습니다. A&P II 두번째로 어렵다고 하는 수업이긴 했지만 생각보다 어렵지는 않았고, 교과서를 읽고 이해하면 시험 보는데에는 문제없이 패스할 수 있는 수업이였습니다. 과제도 많긴 했지만 어렵지는 않아서 과제 확인민 잘 하면 따라가는데에는 문제 없었습니다. Lab 또한 세균 등등을 실험하면서 배우는 수업이라 개인적으로는 재미있었고, 이해하는데에는 문제가 없었습니다. 매주 숙제가 있었지만 매우매우 쉬웠고, 중간고사, 기말고사가 있었습니다.
1. Contemporary economics (ECON1000)
이 수업은 모든 학생들이 들어야 하는 교양이였습니다. 저는 모두가 추천하는 Thomas Garr 교수님을 수강해서 그런만큼 수업도 매우매우 재미있고, 3번의 온라인 시험으로 점수를 받는데 강의를 이해만 하면 좋은 점수를 받는데에는 문제가 없습니다. 다른 교수님들의 수업들은 더 어렵다고 하는 사람들도 많아서 이 교수님 제한으로의 리뷰입니다.
1. Honors discovery
이 수업은 honors college를 위해서 수강한 수업으로 5주간만 매주 진행했고, pass/fail 수업이여서 강의만 듣기만 하면 패스할 수 있는 수업이였습니다. 주제는 환경과 오염에 대한 수업으로 주로 논의하는 수업이였습니다.
1. Introduction to psychology (PSYC1101)
간호대 필수 수업으로 심리학을 배워야 했는데 온라인으로 수업을 들었습니다. 매주 과제와 퀴즈를 해야 했고. 3번의 시험으로 점수를 받았습니다. 교수님이 학기 초에 바뀌고 다른 교수님을 배정 받아 시험이 많이 어려워서 애먹었습니다. 내용 자체는 흥미로워서 좋은 교수님만 만나게된다면 재미있는 수업이 될 수 있겠지만 내용 자체도 굉장히 외워야할 것이 많아서 a&p ii와 미생물학과 같이 듣는 건 많이 버거웠습니다. 이 수업은 1학년에 듣고 끝내는 것을 추천합니다.
<와이즈웨이>에서는 여러분의 미국 유학을
성공적으로 이끌어 주기 위해 다양한 지원을 하고 있습니다.
지난 15 년간 와이즈웨이 장학생들은 미국 주립대에 입학해 "전과목 A" 를 올리고,
졸업후에는 미국 현지 기업과 병원에 취업하고
영주권까지 받는 장학생이 많이 나오고 있습니다.
최근에는 <아마존> 과 <딜로이트> 등 세계적인 기업에 취업한 학생,
조지아텍 박사과정에 전액 장학생으로 진학하고
생할보조비 (Stipend) $35,000 까지 받는 장학생이 나오고 있습니다.
이에 따라
HYPS 명문 대학 진학을 목표로 공부하고 있는 미국 조기 유학생들도
대거 와이즈웨이로 몰리고 있습니다.
다만 여기서 주의해 주실 것은~
인스테이트 장학혜택을 받는 것부터 "전과목 A" 올리는 일, 졸업후 미국 취업과 영주권을 받는 등 <성공 사례> 들은 단순히 높은 토플이나 SAT 성적이 있다고 해서 결코 혼자 이룰 수 있는 것은 아니라는 점을 강조해 드립니다.
와이즈웨이에 관심있는 학생/ 학부모님들은
홈페이지에서 참가신청서를 작성해 제출해 주시고
성적을 메일로 보내 주시면
GPA 등을 계산하여 자세하게 전공에 대한 상담과 컨설팅을 해 드립니다.
장학생으로 선발되면 참가비를 입금하고 등록을 합니다.
등록한 학생들에게는 토플과 SAT 점수 관리를 해주고,
매월 Essay Writing 을 통해 대학 지원에 필요한 EC, RESUME 등을
코칭해 주고 있습니다.
그리고 매월 열리는 설명회에 참석하세요.

2024년 첫번째 설명회는 1월 27일 (토) 카페 진락에서 예정되어있습니다 !
미국 주립대 in-state 장학혜택을 받는 Wise Way 장학생으로 선발되면
1년에 700 ~ 1,000 만원 정도의 학비가 듭니다.

여기에 기숙사비와 보험료등을 합치면
1년에 1,800~2,800 만원 정도가 되어,
국내 사립대학 수준의 학비로 미국 주립대에 유학할 수 있습니다.
미국주립대 장학 유학과 취업에 관련된 정보를 찾으신다면,
와이즈웨이 홈페이지(www.wiseway.co.kr) 나
전화 02-2118-8311, 혹은 아래 오픈 채팅 상담으로 연락주세요!
1:1 상담 오픈채팅
https://open.kakao.com/o/sJqCrCAc
라미웰
#미국주립대장학유학 #와이즈웨이
open.kakao.com
'공지사항' 카테고리의 다른 글
와이즈웨이 수속 비용은 얼마입니까? (0) | 2024.01.17 |
---|---|
141회 설명회 ~ 2024년 9월 학기 및 2025년 1월/9월학기 미국 주립대 장학생 모집!!! (4) | 2024.01.16 |
2024년 TOEFL 시험 일정 (2) | 2024.01.09 |
2024년 ACT 시험 일정 (0) | 2023.12.13 |
2024년 IELTS 시험 일정 (0) | 2023.12.13 |